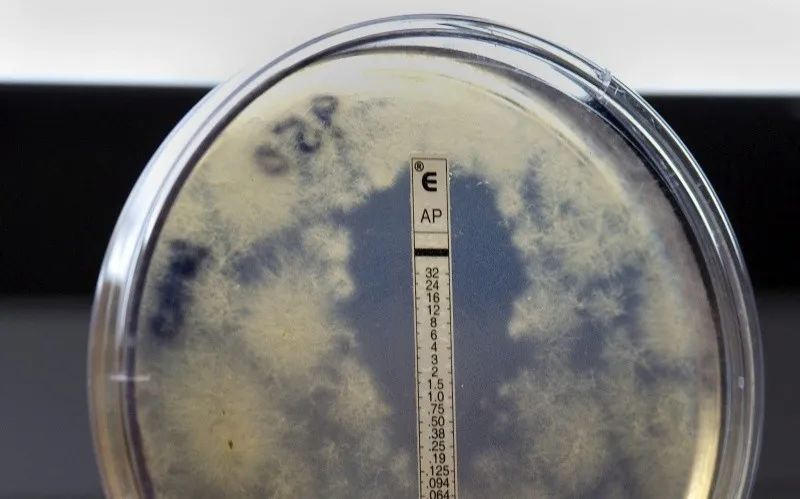

BROTE DE MENINGITIS EN REINO UNIDO CAUSA ALERTA; PISTAS SOBRE SU ORIGEN
En la ciudad de Canterbury, al sureste de Inglaterra, las mascarillas y las filas por medicamentos evocan imágenes de la pandemia por COVID-19, pero esta vez debido a un brote de meningitis que ya ha cobrado la vida de dos jóvenes y mantiene hospitalizadas a otras 13 personas.
El brote fue descrito el miércoles como un hecho sin precedentes por el secretario de Salud del Reino Unido, Wes Streeting, debido al elevado número de casos surgidos en tan poco tiempo: el primer contagio se confirmó apenas el viernes 13 de marzo y, para el martes 17, ya se habían registrado 20 casos.
La enfermedad es conocida por afectar principalmente a adolescentes y adultos jóvenes, y en este caso el epicentro de los contagios apunta a la Universidad de Kent y al bar Club Chemistry.
Una de las víctimas mortales, un hombre de 21 años, era estudiante de dicha institución; la otra, una mujer de 18 años, estaba inscrita en una escuela cercana. Asimismo, muchos de los afectados asistieron al bar entre el 5 y el 7 de marzo. Ante ello, médicos de todo el país recibieron la instrucción de recetar antibióticos a cualquier persona que haya visitado el Club Chemistry en esas fechas, así como a estudiantes de la Universidad de Kent.
La bacteria meningocócica B (MenB) fue identificada como la causante del brote. No obstante, los científicos han señalado que aún es demasiado pronto para determinar si la cepa detectada en Kent es más virulenta que otras.
Se espera que el número de casos aumente porque el periodo de incubación de la infección puede ser de hasta 14 días.
Autoridades llaman a la calma, pero alertan sobre la posible propagación
El ministro de Salud británico, Wes Streeting, anunció una campaña de vacunación dirigida a estudiantes de la Universidad de Kent. Además, explicó que muchos de ellos pertenecen a una generación que no ha recibido esta vacuna, ya que fue introducida en el Reino Unido para bebés y niños pequeños a partir de 2015.
Y aunque las autoridades instaron a la población a no preocuparse innecesariamente, dado que el riesgo general sigue siendo bajo, han aumentado las solicitudes de vacunación en farmacias de todo el país. Mientras tanto, la universidad y otros centros educativos afectados han suspendido la mayor parte de sus actividades, y cientos de jóvenes continúan haciendo fila, como ocurrió ayer, para recibir antibióticos y mascarillas como medida preventiva.
Asimismo, el Servicio Nacional de Salud (NHS) está contactando a decenas de miles de personas en todo el condado para informarles y recomendarles que se sometan a pruebas preventivas.
Uno de los temores es que la infección se propague cuando los estudiantes de otras ciudades salgan de Ketn en las próximas vacaciones de Semana Santa. El propio Streeting declaró que, en los últimos días, se notificó un caso confirmado en Francia, correspondiente a un estudiante de la Universidad de Kent.
¿Qué es la meningitis?
La meningitis es una infección de las membranas que rodean el cerebro y la médula espinal, y puede ser causada por virus o bacterias.
Contraer la enfermedad puede derivar en una infección grave de la sangre llamada sepsis meningocócica, que a menudo se manifiesta como una erupción cutánea y puede poner en peligro la vida si no se trata con rapidez.
La meningitis también puede provocar amputaciones de extremidades en casos graves. Los brotes más peligrosos suelen estar asociados a infecciones bacterianas, como en este caso, donde se ha confirmado que la mayoría de los contagios en Canterbury tienen ese origen.
Se trata de una enfermedad poco frecuente en el Reino Unido —con alrededor de 350 casos al año—, pero que puede propagarse en comunidades estrechas, como residencias universitarias.
Los estudiantes son especialmente vulnerables, ya que la bacteria puede permanecer en la nariz o la garganta sin causar síntomas y transmitirse al toser, besar o compartir bebidas.




